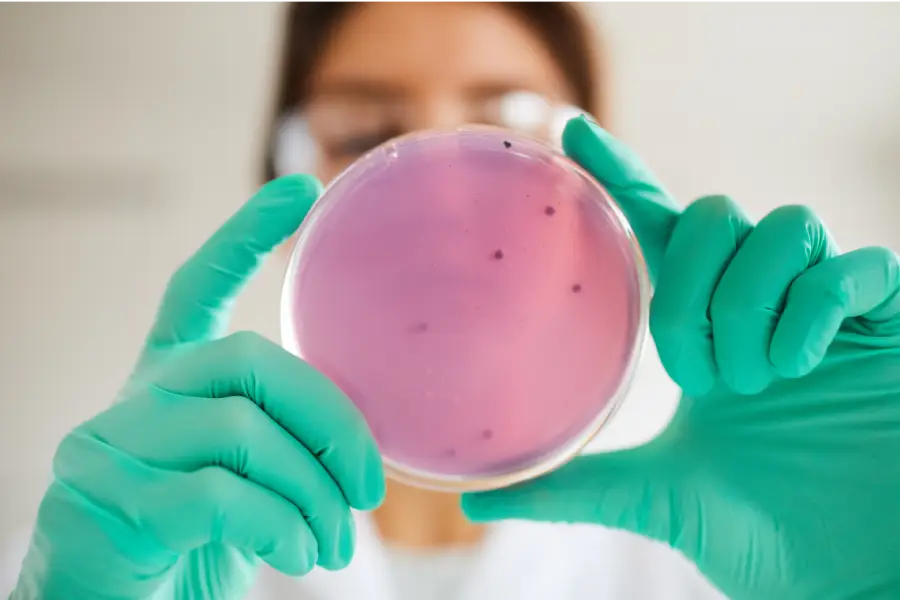

#Reportaje: Instituto de Agroindustria UFRO potencia el emprendimiento femenino rural en La Araucanía

A través de la asociatividad y la innovación, mujeres de distintas comunas de La Araucanía están transformando sus territorios, impulsando negocios sostenibles, fortaleciendo las economías locales y las redes de sus cooperativas.
Universidad de La Frontera titula a once matronas como especialistas en Perinatología

Se celebró la Ceremonia de Titulación de la XII versión del programa de Especialidad en Perinatología, donde 11 matronas recibieron su título que les acredita como especialistas. Además, el programa conmemoró 18 años de vida y de formación de profesionales.
Estudiantes de Pedagogía UFRO destacan en encuentro nacional con proyectos que integran ciencia, tecnología y educación

Delegación obtuvo primer y tercer lugar en el encuentro que reunió a futuras y futuros profesores de todo el país bajo el lema “Tecnología, ciencia y educación”.
Equipos educativos del sur de Chile culminan el año fortaleciendo comunidades de bienestar

El plan, pionero en el país, abarcó jardines infantiles, escuelas rurales, liceos técnico-profesionales y establecimientos dependientes de los Servicios Locales de Educación Pública en más de 15 comunas del sur de Chile.
UFRO impulsa servicio de Análisis Avanzado de Imágenes de Microtomografía Computarizada

Esta iniciativa pionera en el país junto con impulsar la investigación multidisciplinaria busca superar la barrera técnica del software complejo, acelerando la investigación en áreas como odontología, medicina y ciencias agropecuarias al entregar resultados de mediciones críticas (lineales, volumétricas, porosidad y fracturas) de forma especializada y oportuna.
UFRO y Sociedad de Biología de Chile convocan a seminario internacional sobre ecología microbiana aplicada
El 4th Applied Microbial Ecology Webinar: Exploring the Ecology of the Microbial World se desarrollará en modalidad híbrida, el 2 de diciembre en el Campus Andrés Bello de la Universidad de La Frontera (Temuco) y el 3 de diciembre en el Campus Pucón de la misma institución.
Participación en salud: profesionales y dirigentes comunitarios del sur de Chile se reunen en la Facultad de Medicina

Una jornada de análisis y diálogo fue la que se vivió en la Facultad de Medicina con la presencia de distintos actores del mundo académico, de dirigentes sociales y líderes del sector salud para promover la participación de la comunidad.
Carrera de Obstetricia y Puericultura UFRO se suma activamente a campaña de prevención del cáncer de mama

Una activa participación tuvo la carrera de Obstetricia y Puericultura de la Universidad de La Frontera en las distintas acciones que se realizaron en el marco del mes “Octubre rosa” que se desarrolla todos los años para concientizar sobre la prevención y detección temprana del cáncer de mama.
UFRO ofrece curso gratuito y permanente sobre Ciencia Abierta para promover la democratización del conocimiento

Con el objetivo de fortalecer la cultura de apertura en la investigación y promover la difusión responsable del conocimiento científico, la Universidad de La Frontera ofrece el curso gratuito “Introducción a la Ciencia Abierta”, disponible en formato MOOC (Massive Open Online Course). Esta instancia forma parte de los recursos educativos abiertos impulsados por la Vicerrectoría […]
II Congreso Internacional de Ciencias de la Rehabilitación reune a más de 150 participantes de Chile y el mundo

Con gran éxito se llevó a cabo la segunda versión del Congreso Internacional de Ciencias de la Rehabilitación, evento organizado por el Departamento de Ciencias de la Rehabilitación de la Universidad de La Frontera, que reunió a más de 150 participantes de Chile y el extranjero. Bajo el lema “De la evidencia a la innovación”, […]
UFRO desarrolla proyecto con pueblos Changos, Selk’nam y Afrodescendientes para fortalecer la educación en contextos interculturales

La iniciativa, desarrollada en convenio con la Subsecretaría de Educación, contempla trabajo en terreno con comunidades del norte y sur del país y el diseño de materiales didáctico-comunicacionales elaborados por estudiantes y académicos del doctorado, enfocados en fortalecer los procesos educativos interculturales.

